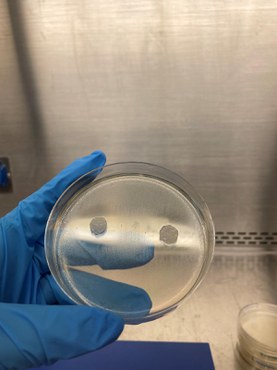

Jornal da USP
10/05/2024

Tido como tratamento inovador na psiquiatria para a depressão, na neurologia e fisioterapia (dores crônicas e doenças neuromusculares), a Estimulação Magnética Transcraniana (EMT) deve contar a partir de agora com robô e câmeras especiais para localizar as pequenas regiões cerebrais que a técnica não invasiva permite tratar, diagnosticar ou ainda estudar. Estas foram as respostas encontradas pelos pesquisadores da USP em Ribeirão Preto para a principal limitação da técnica: a operação manual do equipamento e o uso de sensores fixos na cabeça do paciente poderiam acarretar imprecisão local no posicionamento do estímulo.
Para garantir maior precisão e confiabilidade do uso da EMT, o especialista em física médica Renan Matsuda propôs e desenvolveu durante a pesquisa de seu doutorado pela Faculdade de Filosofia Ciências e Letras de Ribeirão Preto (FFCLRP) da USP um sistema robotizado que utiliza imagens de ressonância magnética para orientar a estimulação do cérebro.
Matsuda conta que na técnica existente hoje, a mais tradicional, a bobina que produz o campo magnético é operada manualmente. Como o uso é muito específico para estimular pequenas regiões, variações no movimento durante o procedimento podem ocasionar resultados diferentes. Mesmo com técnicas mais modernas, como a neuronavegação, que utiliza imagens de ressonância magnética para mostrar o local certo e garantir o posicionamento da EMT em sessões mais longas, e também devido ao peso do estimulador, podem acontecer pequenos deslocamentos.
“Já que no posicionamento manual é inevitável que erros aconteçam, surgiu essa motivação: por que não usar um sistema robótico colaborativo para automatizar esse posicionamento baseado no sistema de neuronavegação, ou seja, nas imagens de ressonância magnética do paciente?”, informa o físico, adiantando que a grande vantagem de utilizar um robô é a garantia precisa que ele sempre vai estar no local desejado e que os estímulos só serão efetuados quando atingir a posição alvo desejada.
Precisão e segurança com sistema de código aberto
O pesquisador destaca, entre os benefícios de sua criação, o sistema de código aberto, o que significa que “outras pessoas podem utilizá-lo, modificá-lo e contribuir para o seu aprimoramento”. Para o físico, o software de código aberto é uma maneira mais acessível às novas tecnologias e que vai contra os sistemas disponíveis hoje comercialmente, tornando a tecnologia mais simples e flexível para diferentes pesquisas e aplicações terapêuticas. “Sempre estamos pensando em novos protocolos, novos desenhos experimentais e os sistemas fechados não têm essa flexibilidade de poder utilizar da maneira que pensamos, desenhamos aquele experimento”, pontua.
Outro fator relevante do código aberto, segundo Matsuda, é a redução de custos. “Claro que precisa adquirir os equipamentos, comprar o robô, os estimuladores, as câmeras para o sistema de posicionamento, mas isso já diminui bastante esse custo”. Somado ao software de código aberto, o pesquisador lembra que o robô é pequeno e fácil de transportar. “Conseguimos facilmente transitar ele entre diferentes salas e até diferentes centros, o que traz também uma questão de logística muito importante falando em estudos.”
Com relação à segurança de utilização do novo equipamento, o físico destaca a possibilidade de operação conjunta com seres humanos. O robô, chamado pelos pesquisadores de ‘colaborativo’, possui ainda várias camadas de segurança integradas e automáticas, como a capacidade de detectar colisões e interromper o movimento se necessário. Também conta com um botão de emergência ao alcance do paciente, garantindo que ele possa interromper o procedimento caso sinta algum desconforto.
O estudo que deu origem ao robô pode ser conferido pela publicação na Brain Stimulation de abril deste ano.
Câmeras inteligentes para neuronavegação
Para guiar a estimulação, é preciso um equipamento que ligue o mundo real ao virtual, que é a imagem do cérebro do paciente. Os equipamentos normalmente usam rastreadores com câmeras infravermelhas, “mas fixar os marcadores na cabeça do paciente pode ser complicado”, adianta Matsuda.
A proposta então foi usar Inteligência Artificial (IA) e a criação de um sistema especial que o pesquisador batizou de MarLe. Ele utiliza uma câmera simples, como uma webcam, para localizar a cabeça do paciente sem a necessidade de marcadores, tornando o procedimento mais simples e rápido, além de aumentar a precisão. “Com essa técnica que chamamos de MarLe, conseguimos remover essa necessidade (do uso de fixadores na cabeça) e garantir ainda mais a confiabilidade da técnica”, informa.
É que, segundo Matsuda, todos os sistemas utilizados até agora necessitam de algum tipo de fixação de marcadores na cabeça do paciente e estão sujeitos a erros durante o procedimento caso o marcador se movimente. “Perdemos o registro e não garante que a gente esteja indicando de maneira precisa o local desejado”, acrescenta o pesquisador, explicando sua proposta de usar a Inteligência Artificial (IA) em uma rede treinada de detecção facial. A equipe de Matsuda utilizou câmeras de baixo custo para localizar a cabeça do paciente, garantindo precisão e dispensando os marcadores fixos.
Assim, o sistema MarLe utiliza técnicas de visão computacional, acessando em tempo real, informado pelas imagens prévias de ressonância magnética, os locais no cérebro a serem estudados ou estimulados. Mais detalhes sobre o MarLe estão no artigo publicado pela Physical and Engineering Sciences in Medicine.
O estudo Sistema Robotizado para Estimulação Magnética Transcraniana Navegada, realizado por Matsuda durante seu doutorado, foi apresentado à FFCLRP em 2022. O pesquisador trabalhou sob orientação do professor Oswaldo Baffa Filho e coorientação de Victor Hugo Souza, pesquisador da Aalto University na Finlândia. Contou também com apoio da NeuroMat, Centro de Pesquisa, Inovação e Difusão em Neuromatemática (CEPID NeuroMat) fundado em 2013 na Universidade de São Paulo e financiado pela Fundação de Amparo à Pesquisa do Estado de São Paulo (FAPESP). O NeuroMat se dedica a integrar modelagem matemática e neurociência.
A pesquisa recebeu o prêmio Grande Área – Inovação da 12ª edição do Prêmio Tese Destaque USP. [1], [2]
[1] Texto de Susanna Nazar
[2] Publicação original: https://jornal.usp.br/ciencias/cientistas-criam-sistema-robotizado-para-guiar-estimulacao-transcraniana/
Como citar este texto: Jornal da USP. Cientistas criam sistema robotizado para guiar estimulação transcraniana. Texto de Susanna Nazar. Saense. https://saense.com.br/2024/05/cientistas-criam-sistema-robotizado-para-guiar-estimulacao-transcraniana/. Publicado em 10 de maio (2024).